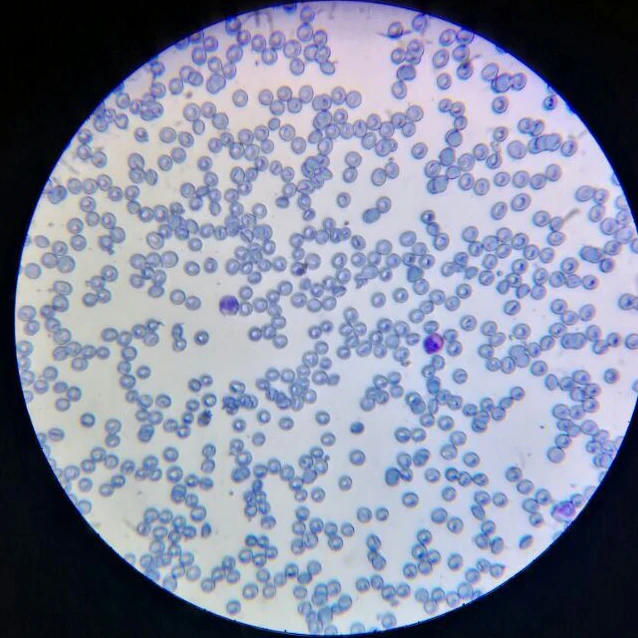
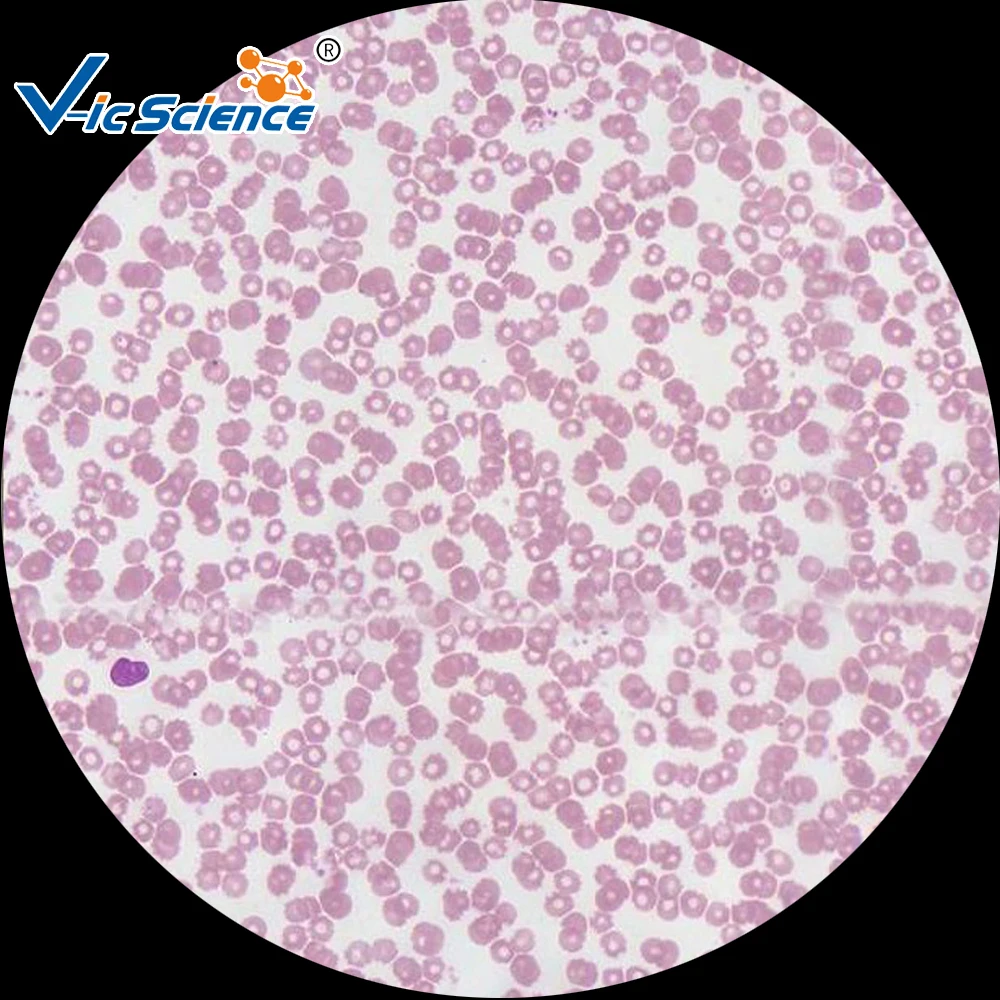

Déclencheur pour wobblers ROSE 1000g
OGCtfFQygyAller sur le site internet (page produit) »

Aller sur le site internet (page produit) »
Цвет: черныйСостав набора: кормушка; крючок; коромысло; леска; вертлюг; стопорТип: набор оснасткиНазначение: карп; карась; лещ; плотваСтрана-производитель: КитайМатериал: пластик; нейлон; металл
Aller sur le site internet (page produit) »







Aller sur le site internet (page produit) »
Aller sur le site internet (page produit) »

Aller sur le site internet (page produit) »
Aller sur le site internet (page produit) »
Extracteur De Filtre À Huile Faucille Autovirazh Autovirazh Art Av 011728 11 21
Armoires Porte Intérieure Armoires 778 Chêne Émaillé 11 21
Attaquant Makita 324901 1 11 21
Sweat Unisexe Coolpodarok W013314 Blanc 46 Ru 11 22
Ordinateur De Jeu Dixet Dx G 45435146 Intel Core I3 13100 Nvidia Geforce Rtx 4090 24 576 Mo 64 Go Ddr5 11 22
Ordinateur De Jeu Dixet Dx G 45614392 Intel Core I7 13700Kf Nvidia Geforce Rtx 3060Ti 8 192 Mo 128 Go Ddr4 11 22
Silent Bloc De Levier Inférieur Avant 4521290 Ford 4521290 11 22
Ordinateur De Jeu Dixet Dx G 45427395 Intel Core I3 13100 Nvidia Geforce Rtx 3050 8192 Mo 128 Go Ddr4 11 22
Matelas Sommeil Repos Colorado 80X186 11 22
Ordinateur De Jeu Dixet Dx G 45595962 Intel Core I7 13700 Amd Radeon Radeon Rx 6900Xt 16384 Mo 128 Go Ddr4 11 22
Ordinateur De Jeu Dixet Dx G 45407443 Intel Core I3 13100F Amd Radeon Rx 6600 8192 Mo 64 Go Ddr4 11 22
Ordinateur De Jeu Dixet Dx G 45683644 Intel Core I9 13900Kf Amd Radeon Amd Radeon Rx 6750Xt 12288 Mo 16 Go Ddr4 11 23
Roulement De Roue Kit Suzuki Baleno Eg 95 Liana Er 01 Swift Ah Aj 90 11 23
Ordinateur De Jeu Dixet Dx G 45442237 Intel Core I5 13400F Nvidia Geforce Gtx 1660 6144 Mo 32 Go Ddr4 11 23
Ordinateur De Jeu Dixet Dx G 45435859 Intel Core I3 13100 Nvidia Geforce Rtx 3070Ti 8192 Mo 64 Go Ddr5 11 23
Ordinateur De Jeu Dixet Dx G 45614638 Intel Core I7 13700Kf Nvidia Geforce Rtx 4070Ti 12288 Mo 128 Go Ddr4 11 23
Ordinateur De Jeu Dixet Dx G 45416210 Intel Core I3 13100F Nvidia Geforce Gtx 1660 Super 6144 Mo 64 Go Ddr5 11 23
Ordinateur Puissant Pour Les Jeux Bonuspk 3754343 Core I5 10400F B560M 16 Go Ssd 1 To Rx 6700Xt Sans Système Dexploitation Wi F 11 23
Ordinateur De Jeu Dixet Dx G 45432886 Intel Core I3 13100 Nvidia Geforce Rtx 3060Ti 8192 Mo 32 Go Ddr5 11 23
Ordinateur De Jeu Dixet Dx G 45638134 Intel Core I7 13700K Nvidia Geforce Rtx 3070 8192 Mo 16 Go Ddr5 11 23
Ordinateur De Jeu Dixet Dx G 45463457 Intel Core I5 13400 Nvidia Geforce Gt 1030 2048 Mo 64 Go Ddr4 11 24
Costume Gorka Taille 48 50 182 188 11 24
Thermos Xiaomi Kiss Kiss Moka Smart Cup 430 Ml Sp U45Cw Blanc 11 25
Hyundai Porter Broche De Câble De Frein De Stationnement Oe 11 25
Foton Capteur De Pression De Rampe De Carburant Isf 38 E4 O Foton 11 25
T Shirt Enfant Printio Pocket Santa Couleur Blanc R 104 11 25
Kale Radiateur De Climatisation Renault Fluence Megane Iii Megane Cc Scenic Iii 11 25
Porte Balai De Démarrage Krauf Shn0439Mg 11 26
Thermostat Fenox Ts209 1 Pièce 11 26
Lien Stabilisateur Avant Hola Ls12 019 Hola Art Ls12 019 11 26
Extracteur De Filtre À Huile Faucille Autovirazh Autovirazh Art Av 011728 11 21
Armoires Porte Intérieure Armoires 778 Chêne Émaillé 11 21
Attaquant Makita 324901 1 11 21
Sweat Unisexe Coolpodarok W013314 Blanc 46 Ru 11 22
Ordinateur De Jeu Dixet Dx G 45435146 Intel Core I3 13100 Nvidia Geforce Rtx 4090 24 576 Mo 64 Go Ddr5 11 22
Ordinateur De Jeu Dixet Dx G 45614392 Intel Core I7 13700Kf Nvidia Geforce Rtx 3060Ti 8 192 Mo 128 Go Ddr4 11 22
Silent Bloc De Levier Inférieur Avant 4521290 Ford 4521290 11 22
Ordinateur De Jeu Dixet Dx G 45427395 Intel Core I3 13100 Nvidia Geforce Rtx 3050 8192 Mo 128 Go Ddr4 11 22
Matelas Sommeil Repos Colorado 80X186 11 22
Ordinateur De Jeu Dixet Dx G 45595962 Intel Core I7 13700 Amd Radeon Radeon Rx 6900Xt 16384 Mo 128 Go Ddr4 11 22
Ordinateur De Jeu Dixet Dx G 45407443 Intel Core I3 13100F Amd Radeon Rx 6600 8192 Mo 64 Go Ddr4 11 22
Ordinateur De Jeu Dixet Dx G 45683644 Intel Core I9 13900Kf Amd Radeon Amd Radeon Rx 6750Xt 12288 Mo 16 Go Ddr4 11 23
Roulement De Roue Kit Suzuki Baleno Eg 95 Liana Er 01 Swift Ah Aj 90 11 23
Ordinateur De Jeu Dixet Dx G 45442237 Intel Core I5 13400F Nvidia Geforce Gtx 1660 6144 Mo 32 Go Ddr4 11 23
Ordinateur De Jeu Dixet Dx G 45435859 Intel Core I3 13100 Nvidia Geforce Rtx 3070Ti 8192 Mo 64 Go Ddr5 11 23
Ordinateur De Jeu Dixet Dx G 45614638 Intel Core I7 13700Kf Nvidia Geforce Rtx 4070Ti 12288 Mo 128 Go Ddr4 11 23
Ordinateur De Jeu Dixet Dx G 45416210 Intel Core I3 13100F Nvidia Geforce Gtx 1660 Super 6144 Mo 64 Go Ddr5 11 23
Ordinateur Puissant Pour Les Jeux Bonuspk 3754343 Core I5 10400F B560M 16 Go Ssd 1 To Rx 6700Xt Sans Système Dexploitation Wi F 11 23
Ordinateur De Jeu Dixet Dx G 45432886 Intel Core I3 13100 Nvidia Geforce Rtx 3060Ti 8192 Mo 32 Go Ddr5 11 23
Ordinateur De Jeu Dixet Dx G 45638134 Intel Core I7 13700K Nvidia Geforce Rtx 3070 8192 Mo 16 Go Ddr5 11 23
Ordinateur De Jeu Dixet Dx G 45463457 Intel Core I5 13400 Nvidia Geforce Gt 1030 2048 Mo 64 Go Ddr4 11 24
Costume Gorka Taille 48 50 182 188 11 24
Thermos Xiaomi Kiss Kiss Moka Smart Cup 430 Ml Sp U45Cw Blanc 11 25
Hyundai Porter Broche De Câble De Frein De Stationnement Oe 11 25
Foton Capteur De Pression De Rampe De Carburant Isf 38 E4 O Foton 11 25
T Shirt Enfant Printio Pocket Santa Couleur Blanc R 104 11 25
Kale Radiateur De Climatisation Renault Fluence Megane Iii Megane Cc Scenic Iii 11 25
Porte Balai De Démarrage Krauf Shn0439Mg 11 26
Thermostat Fenox Ts209 1 Pièce 11 26
Lien Stabilisateur Avant Hola Ls12 019 Hola Art Ls12 019 11 26